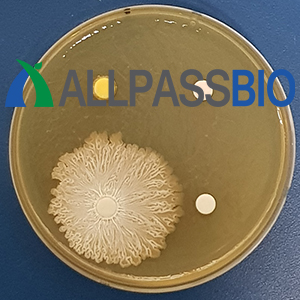

안녕하세요, #올패스바이오 #AllpassBio 입니다.
시험, 검사, 분석, 효능평가 등을 의뢰받아 진행하다보면 #시료오염 이 확인되는 경우가 있습니다.
제품을 개발하기 위한 시료들이기에 일정 수준으로 오염이 되어 있는 것이야 법적으로 기준 이하인 경우에는 별 문제가 되지 않을수도 있지만
시료를 구입해서 시험을 진행하는 과정에서 미생물 오염이 확인되면 좋은 증상은 아니지 않나 생각됩니다.
천연물 시료는 보관을 위해서 당을 첨가하거나 #화장품에 사용하는 시료들은 #1,2 Hexanediol 을 일반적으로 사용하는 것 같습니다만,
원료가 미생물의 오염이 적거나 없어야 제조 과정에서의 발생될 수 있는 미생물 오염이라는 항목이 관리하기가 쉽지 않나 생각됩니다.
좋은 제품을 위한 시작, 시료의 관리부터가 중요합니다.